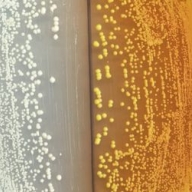
������ ������� ������� ������ ������������� ���������

Дальнейший синтез таких препаратов как морфий или кодеин из ретикулина не представляет для ученых особой проблемы
В США ученые научили обычные дрожжи синтезировать наркотики. Микробиологическая "фабрика" способна создавать морфий, сообщает "Подробности".
Специалистам удалось осуществить первые этапы синтеза опиоидов при помощи дрожжей, наладив выработку S-ретикулина из глюкозы.
Затем модифицировав ДНК пивных дрожжей ученые заставили их вырабатывать фермент и добились превращения глюкозы в дофамин, а позже эти дрожжи "научились" вырабатывать S-ретикулин.
Как сообщают ученые, дальнейший синтез таких препаратов как морфий или кодеин из ретикулина не представляет для ученых особой проблемы. Этот способ позволит создавать труднодоступные лекарства, на разработку которых требуются дорогостоящее оборудование и много времени.
Тем не менее, ученые обеспокоились, что такой простой способ выращивания наркотических веществ в домашних условиях может повлиять на их распространение – почти каждый сможет создавать без особых знаний в химии и биологии.
Поэтому секрет генномодифицированных дрожжей сейчас держится в тайне, чтобы они не попали в злые руки.
Источник: Сегодня
21.05.2015 09:36